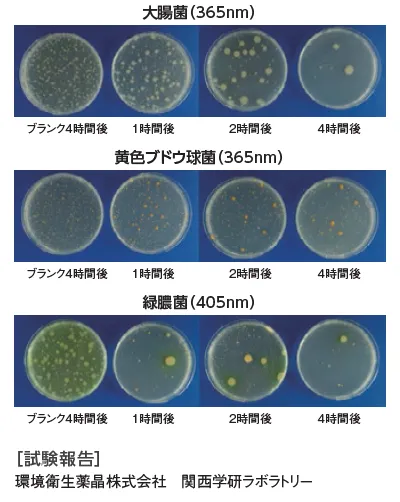

除菌装置付きLED照明 ウイルス除菌隊
- 製品名
- 除菌装置付きLED照明
- 型式
- ウイルス除菌隊
- メーカー
- 株式会社飯田照明
- メーカーロゴ
-

- メーカーサイト
- メーカー製品サイトはこちら
概要
UV-A&光触媒のダブルウイルス除菌システムで室内の空気を除菌・消臭
特長
・日亜化学工業製 高効率LED採用
・本製品はウイルス除菌の他、大腸菌や黄色ブドウ球菌などの除菌にも有効であり、人や照射物に影響の少ないUV-A(365~405nm)を採用する事で、安心してご使用頂けます。
・メンテナンスフリー。フィルタや化学薬品等の交換は必要ありません。
・環境に優しい。水銀等の有害物質を含んでいません。
主な仕様
【直管型】

【スタンド型】

【卓上ボックス型】

【ポータブル型】